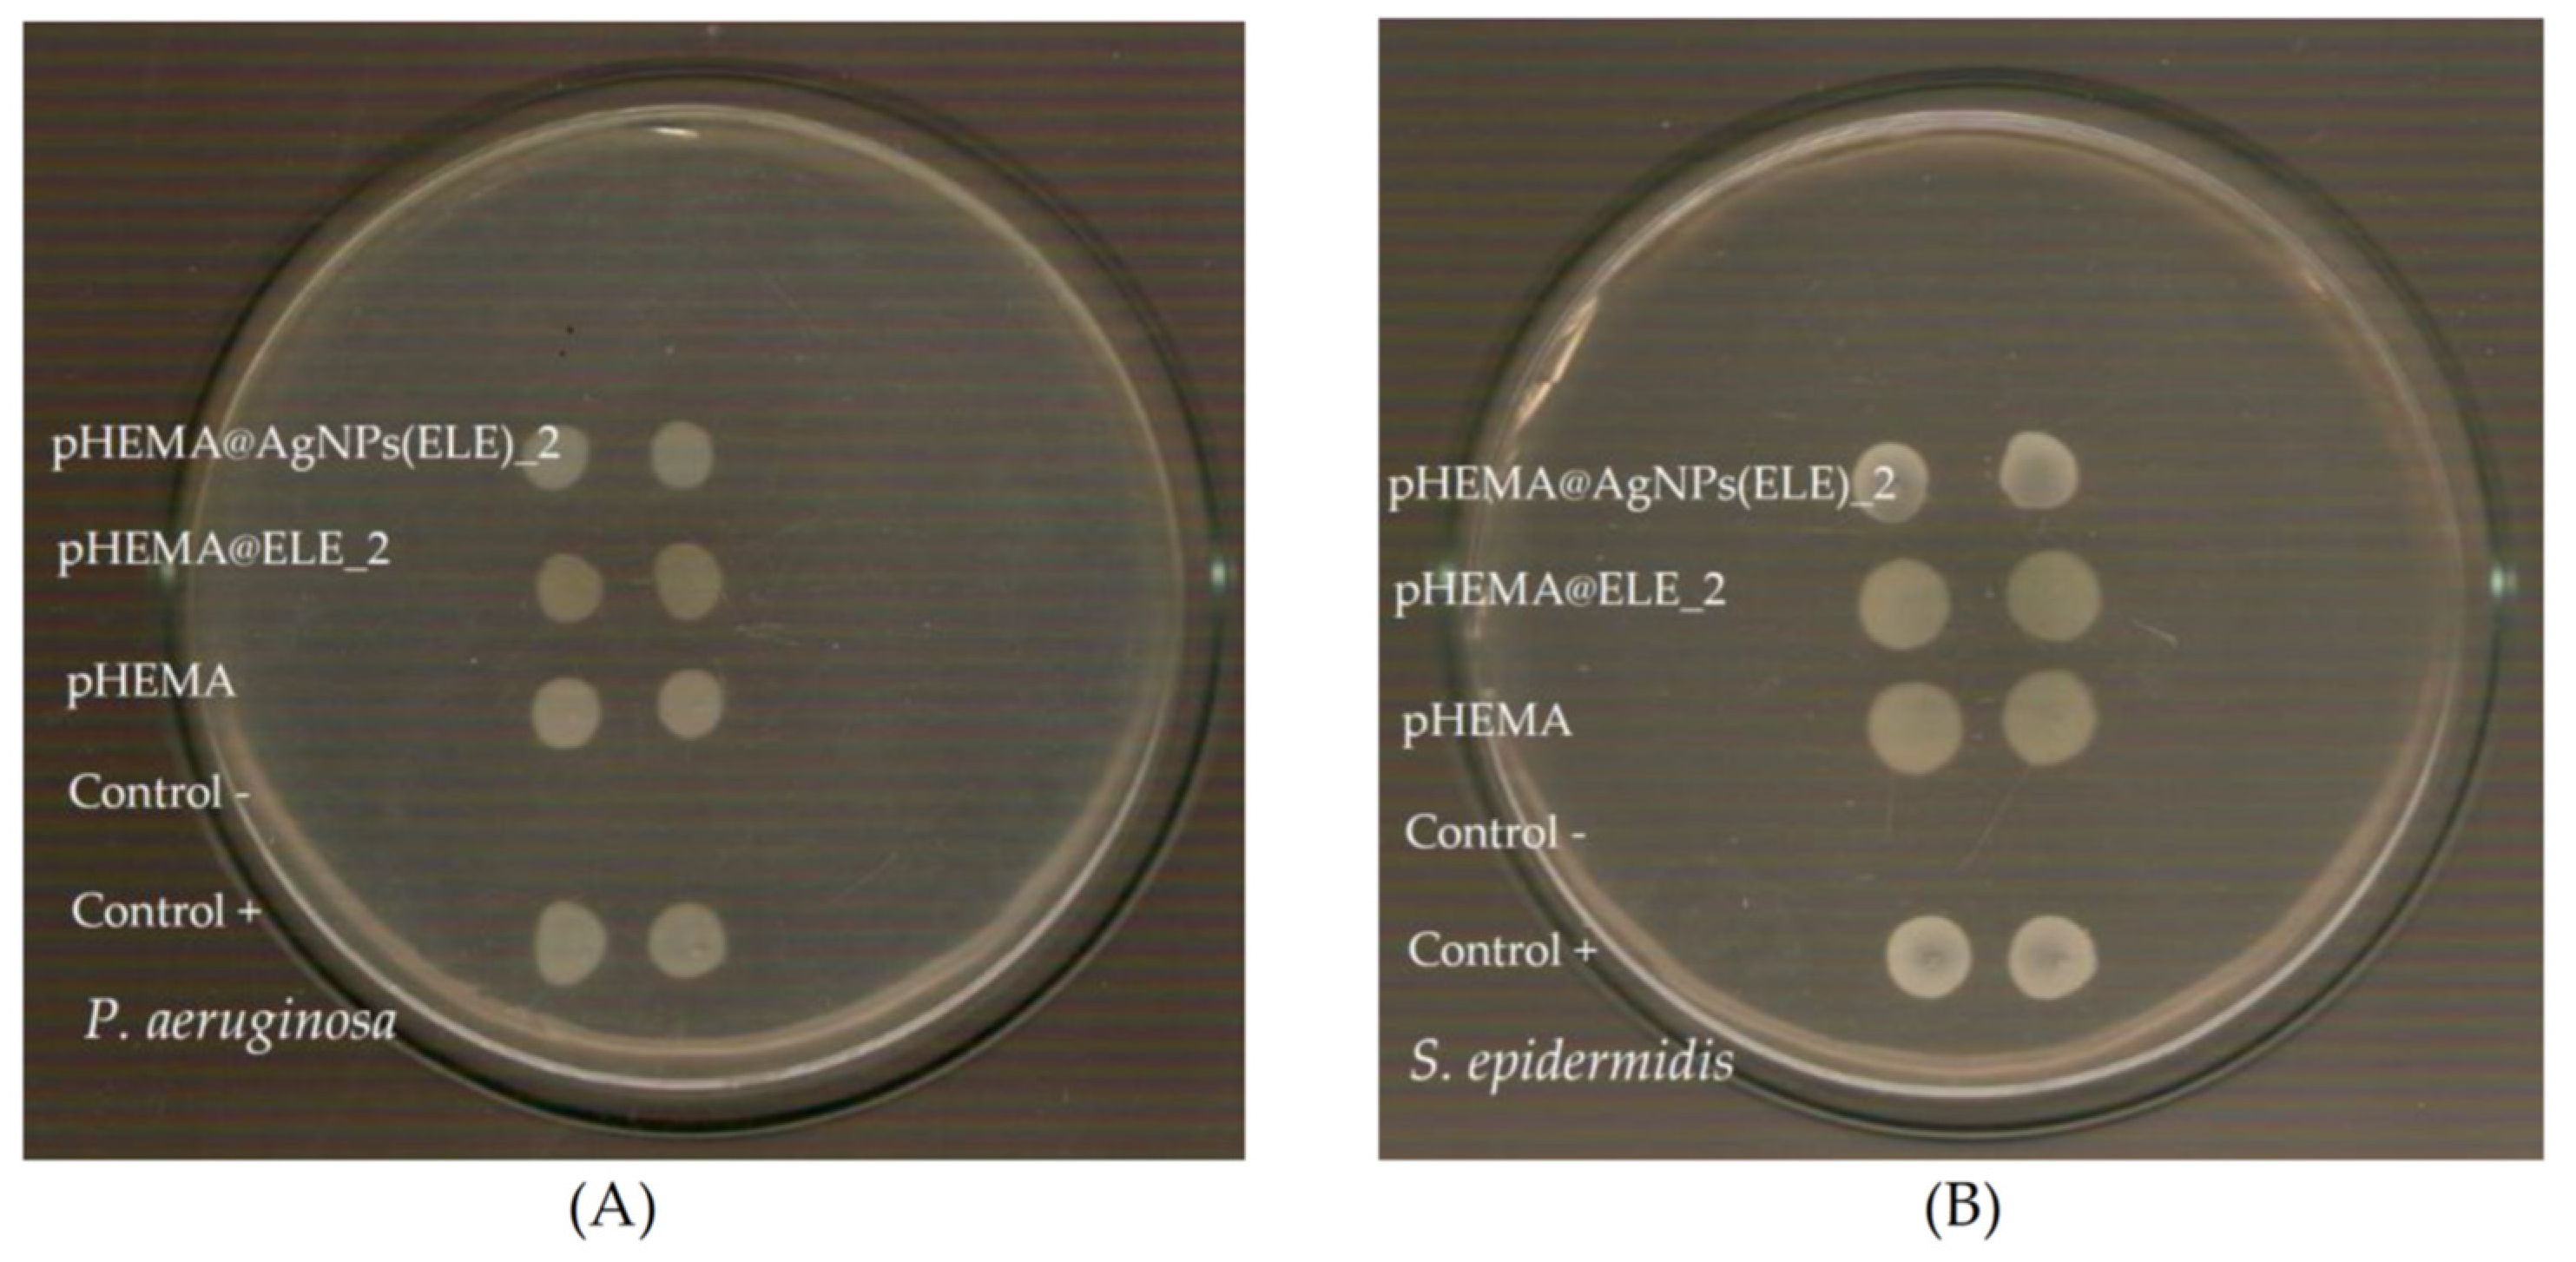
Molecules 26 05022 g007 550

Silver Nanoparticles Using Eucalyptus or Willow Extracts (AgNPs) as Contact Lens Hydrogel Components to Reduce the Risk of Microbial Infection
Abstract
:1. Introduction
2. Results
2.1. General Aspects
2.2. X-ray Fluorescence Spectroscopy
2.3. X-ray Powder Diffraction Analysis (XRPD)
2.4. Thermo Gravimetric Analysis of AgNPs(ELE), AgNPs(WBE), pHEMA, pHEMA@AgNPs(ELE)_2 and pHEMA@AgNPs(WBE)_2
2.4.1. Differential Scanning Calorimetry (DSC)
2.4.2. Thermal Decomposition
2.5. Attenuated Total Reflection Spectroscopy (ATR-FTIR)
2.6. Ultraviolet Visible Spectroscopy (UV-vis)
2.7. Antimicrobial Study
2.7.1. Determination of the Inhibition Zone (IZ) through Agar Disc-Diffusion Method
2.7.2. In Vitro Toxicity against Normal Human Corneal Epithelial Cells (HCEC)
3. Experimental Methods
3.1. Materials and Instruments
3.2. Preparation of ELE, WBE and AgNPs(ELE), AgNPs(WBE)
3.3. Biological Tests
3.4. Sulforhodamine B Assay
4. Conclusions
Supplementary Materials
Author Contributions
Funding
Institutional Review Board Statement
Informed Consent Statement
Data Availability Statement
Acknowledgments
Conflicts of Interest
Sample Availability
References
- Zimmerman, A.B.; Nixon, A.D.; Rueff, E.M. Contact lens associated microbial keratitis: Practical considerations for the optometrist. Clin. Optom. 2016, 8, 1–12. [Google Scholar] [CrossRef] [Green Version]
- Schaefer, F.; Bruttin, O.; Zografos, L.; Guex-Crosier, Y. Bacterial keratitis: A prospective clinical and microbiological study. Br. J. Ophthalmol. 2001, 85, 842–847. [Google Scholar] [CrossRef] [PubMed] [Green Version]
- Stapleton, F.; Carnt, N. Contact lens-related microbial keratitis: How have epidemiology and genetics helped us with pathogenesis and prophylaxis. Eye 2012, 26, 185–193. [Google Scholar] [CrossRef] [Green Version]
- Xiao, A.; Dhand, C.; Leung, C.M.; Beuerman, R.W.; Ramakrishna, S.; Lakshminarayanan, R. Strategies to design antimicrobial contact lenses and contact lens cases. J. Mater. Chem. B 2018, 6, 2171–2186. [Google Scholar] [CrossRef]
- Rossos, A.K.; Banti, C.N.; Kalampounias, A.; Papachristodoulou, C.; Kordatos, K.; Zoumpoulakis, P.; Mavromoustakos, T.; Kourkoumelis, N.; Hadjikakou, S.K. pHEMA@AGMNA-1: A novel material for the development of antibacterial contact lens. Mater. Sci. Eng. C 2020, 111, 110770. [Google Scholar] [CrossRef] [PubMed]
- Meretoudi, A.; Banti, C.N.; Raptis, P.K.; Papachristodoulou, C.; Kourkoumelis, N.; Ikiades, A.A.; Zoumpoulakis, P.; Mavromoustakos, T.; Hadjikakou, S.K. Silver nanoparticles from Oregano leaves′ extracts as antimicrobial components for non-infected hydrogel contact lenses. Int. J. Mol. Sci. 2021, 22, 3539. [Google Scholar] [CrossRef] [PubMed]
- Musgrave, C.S.A.; Fang, F. Contact lens materials: A materials science perspective. Materials 2019, 12, 261. [Google Scholar] [CrossRef] [PubMed] [Green Version]
- Wichterle, O.; Lim, D. Hydrophilic gels for biological use. Nature 1960, 185, 117–118. [Google Scholar] [CrossRef]
- Milionis, I.; Banti, C.B.; Sainis, I.; Raptopoulou, C.P.; Psycharis, V.; Kourkoumelis, N.; Hadjikakou, S.K. Silver ciprofloxacin (CIPAG): A successful combination of chemically modified antibiotic in inorganic–organic hybrid. J. Biol. Inorg. Chem. 2018, 23, 705–723. [Google Scholar] [CrossRef]
- Rahimi-Nasrabadi, M.; Pourmortazavi, S.M.; Shandiz, S.A.; Ahmadi, F.; Batooli, H. Green synthesis of silver nanoparticles using Eucalyptus leucoxylon leaves extract and evaluating the antioxidant activities of extract. Nat. Prod. Res. 2014, 28, 1964–1969. [Google Scholar] [CrossRef] [PubMed]
- Dogan, G.; Kara, N.; Bagci, E.; Gur, S. Chemical composition and biological activities of leaf and fruit essential oils from Eucalyptus camaldulensis. Z. Nat. C 2017, 72, 483–489. [Google Scholar] [CrossRef]
- Mo, Y.-Y.; Tang, Y.-K.; Wang, S.-Y.; Lin, J.-M.; Zhang, H.-B.; Luo, D.-Y. Green synthesis of silver nanoparticles using eucalyptus leaf extract. Mater. Lett. 2015, 144, 165–167. [Google Scholar] [CrossRef]
- Salari, M.H.; Amine, G.; Shirazi, M.H.; Hafezi, R.; Mohammadypour, M. Antibacterial effects of Eucalyptus globulus leaf extract on pathogenic bacteria isolated from specimens of patients with respiratory tract disorders. Clin. Microbiol. Infect. 2006, 12, 194–196. [Google Scholar] [CrossRef] [Green Version]
- Masika, P.J.; Afolayan, A.J. Antimicrobial activity of some plants used for the treatment of livestock disease in the Eastern Cape, South Africa. J. Ethnopharmacol. 2002, 83, 129–134. [Google Scholar] [CrossRef]
- Shara, M.; Stohs, S.J. Efficacy and safety of white willow bark (Salix alba) extracts. Phytother. Res. 2015, 29, 1112–1116. [Google Scholar] [CrossRef] [PubMed]
- Eckhardt, S.; Brunetto, P.S.; Gagnon, J.; Priebe, M.; Giese, B.; Fromm, K.M. Nanobio Silver: Its interactions with peptides and bacteria, and its uses in medicine. Chem. Rev. 2013, 113, 4708. [Google Scholar] [CrossRef] [Green Version]
- Wintachai, P.; Paosen, S.; Yupanqui, C.T.; Voravuthikunchai, S.P. Silver nanoparticles synthesized with Eucalyptus critriodora ethanol leaf extract stimulate antibacterial activity against clinically multidrug-resistant Acinetobacter baumannii isolated from pneumonia patients. Microb. Pathog. 2019, 126, 245–257. [Google Scholar] [CrossRef] [PubMed]
- Mohammed, A.E. Green synthesis, antimicrobial and cytotoxic effects of silver nanoparticles mediated by Eucalyptus camaldulensis leaf extract. Asian Pac. J. Trop. Biomed. 2015, 5, 382–386. [Google Scholar] [CrossRef]
- Karetsi, V.A.; Banti, C.N.; Kourkoumelis, N.; Papachristodoulou, C.; Stalikas, C.D.; Raptopoulou, C.P.; Psycharis, V.; Zoumpoulakis, P.; Mavromoustakos, T.; Sainis, I.; et al. An efficient disinfectant, composite material {SLS@[Zn3(CitH)2]} as ingredient for development of sterilized and non infectious contact lens. Antibiotics 2019, 8, 213. [Google Scholar] [CrossRef] [PubMed] [Green Version]
- Shameli, K.; Ahmad, M.B.; Zamanian, A.; Sangpour, P.; Shabanzadeh, P.; Abdollahi, Y.; Zargar, M. Green biosynthesis of silver nanoparticles using Curcuma longa tuber powder. Int. J. Nanomed. 2012, 7, 5603–5610. [Google Scholar] [CrossRef] [PubMed] [Green Version]
- Roy, K.; Sarkar, C.K.; Ghosh, C.K. Plant-mediated synthesis of silver nanoparticles using parsley (Petroselinum crispum) leaf extract: Spectral analysis of the particles and antibacterial study. Appl. Nanosci. 2015, 5, 945–951. [Google Scholar] [CrossRef] [Green Version]
- Ajitha, B.; Ashok Kumar Reddy, Y.; Sreedhara Reddy, P. Biogenic nano-scale silver particles by Tephrosia purpurea leaf extract and their inborn antimicrobial activity. Spectrochim. Acta Part A 2014, 121, 164–172. [Google Scholar] [CrossRef] [PubMed]
- Abdel-Halim, E.S.; Alanazi, H.H.; Al-Deyab, S.S. Utilization of hydroxypropyl carboxymethyl cellulose in synthesis of silver nanoparticles. Int. J. Biol. Macromol. 2015, 75, 467–473. [Google Scholar] [CrossRef] [PubMed]
- Garza-Navarro, M.A.; Aguirre-Rosales, J.A.; Llanas-Vázquez, E.E.; Moreno-Cortez, I.E.; Torres-Castro, A.; González-González, V. Totally ecofriendly synthesis of silver nanoparticles from aqueous dissolutions of polysaccharides. Int. J. Polym. Sci. 2013, 436021. [Google Scholar] [CrossRef] [Green Version]
- Matuschek, E.; Brown, D.F.J.; Kahlmeter, G. Development of the EUCAST disk difusion antimicrobial susceptibility testing method and its implementation in routine microbiology laboratories. Clin. Microbiol. Infect. 2014, 20, o255–o266. [Google Scholar] [CrossRef] [PubMed] [Green Version]
- Wayne, P.A.; Clinical and Laboratory Standards Institute (CLSI). Performance Standards for Antimicrobial Susceptibility Testing; Approved Standard, 25th Informational Supplement, CLSI Document M100–S25; Clinical and Laboratory Standards Institute: Wayne, PA, USA, 2015. [Google Scholar]
- Medici, S.; Peana, M.; Nurchi, V.M.; Antonietta Zoroddu, M. Medical uses of silver: History, myths, and scientific evidence. J. Med. Chem. 2019, 62, 5923–5943. [Google Scholar] [CrossRef]
- Koski, C.; Sarkar, N.; Bose, S. Cytotoxic and osteogenic effects of crocin and bicarbonate from calcium phosphates for potential chemopreventative and anti-inflammatory applications In Vitro and In Vivo. J. Mater. Chem. B 2020, 8, 2048–2062. [Google Scholar] [CrossRef] [PubMed]
- Available online: https://www.iso.org/standard/36406.html (accessed on 19 August 2021).
- Papadimitriou, A.; Ketikidis, I.; Stathopoulou, M.K.; Banti, C.N.; Papachristodoulou, C.; Zoumpoulakis, L.; Agathopoulos, S.; Vagenas, G.V.; Hadjikakou, S.K. Innovative material containing the natural product curcumin, with enhanced antimicrobial properties for active packaging. Mater. Sci. Eng. C 2018, 84, 118. [Google Scholar] [CrossRef]

| P. aeruginosa | S. epidermidis | S. aureus | |
|---|---|---|---|
| Inhibition Zones (mm) | |||
| AgNPs(ELE) | 15.2 ± 1.2 | 17.0 ± 1.1 | 15.2 ± 1.6 |
| ELE | ND | ND | ND |
| AgNPs(WBE) | 11.9 ± 0.9 | 11.3 ± 0.6 | 11.0 ± 0.0 |
| WBE | ND | ND | ND |
| pHEMA@AgNPs(ELE)_2 | 12.3 ± 1.7 | 13.2 ± 1.2 | 13.2 ± 1.4 |
| pHEMA@ELE_2 | ND | ND | ND |
| pHEMA@AgNPs(WBE)_2 | 11.2 ± 0.3 | 11.0 ± 1.0 | 11.5 ± 0.6 |
| pHEMA@WBE_2 | ND | ND | ND |
| Bacteria Viability (%) | |||
| pHEMA@AgNPs(ELE)_2 | 28.3 | 6.8 | 85.3 |
| pHEMA@ELE_2 | 94.6 | 93.5 | 98.7 |
| pHEMA@AgNPs(WBE)_2) | 73.6 | 81.6 | 82.5 |
| pHEMA@WBE_2 | 90.5 | 88.1 | 97.3 |
Publisher’s Note: MDPI stays neutral with regard to jurisdictional claims in published maps and institutional affiliations. |
© 2021 by the authors. Licensee MDPI, Basel, Switzerland. This article is an open access article distributed under the terms and conditions of the Creative Commons Attribution (CC BY) license (https://creativecommons.org/licenses/by/4.0/).
Share and Cite
Rossos, A.K.; Banti, C.N.; Raptis, P.K.; Papachristodoulou, C.; Sainis, I.; Zoumpoulakis, P.; Mavromoustakos, T.; Hadjikakou, S.K. Silver Nanoparticles Using Eucalyptus or Willow Extracts (AgNPs) as Contact Lens Hydrogel Components to Reduce the Risk of Microbial Infection. Molecules 2021, 26, 5022. https://doi.org/10.3390/molecules26165022
Rossos AK, Banti CN, Raptis PK, Papachristodoulou C, Sainis I, Zoumpoulakis P, Mavromoustakos T, Hadjikakou SK. Silver Nanoparticles Using Eucalyptus or Willow Extracts (AgNPs) as Contact Lens Hydrogel Components to Reduce the Risk of Microbial Infection. Molecules. 2021; 26(16):5022. https://doi.org/10.3390/molecules26165022
Chicago/Turabian StyleRossos, Andreas K., Christina N. Banti, Panagiotis K. Raptis, Christina Papachristodoulou, Ioannis Sainis, Panagiotis Zoumpoulakis, Thomas Mavromoustakos, and Sotiris K. Hadjikakou. 2021. "Silver Nanoparticles Using Eucalyptus or Willow Extracts (AgNPs) as Contact Lens Hydrogel Components to Reduce the Risk of Microbial Infection" Molecules 26, no. 16: 5022. https://doi.org/10.3390/molecules26165022
APA StyleRossos, A. K., Banti, C. N., Raptis, P. K., Papachristodoulou, C., Sainis, I., Zoumpoulakis, P., Mavromoustakos, T., & Hadjikakou, S. K. (2021). Silver Nanoparticles Using Eucalyptus or Willow Extracts (AgNPs) as Contact Lens Hydrogel Components to Reduce the Risk of Microbial Infection. Molecules, 26(16), 5022. https://doi.org/10.3390/molecules26165022

